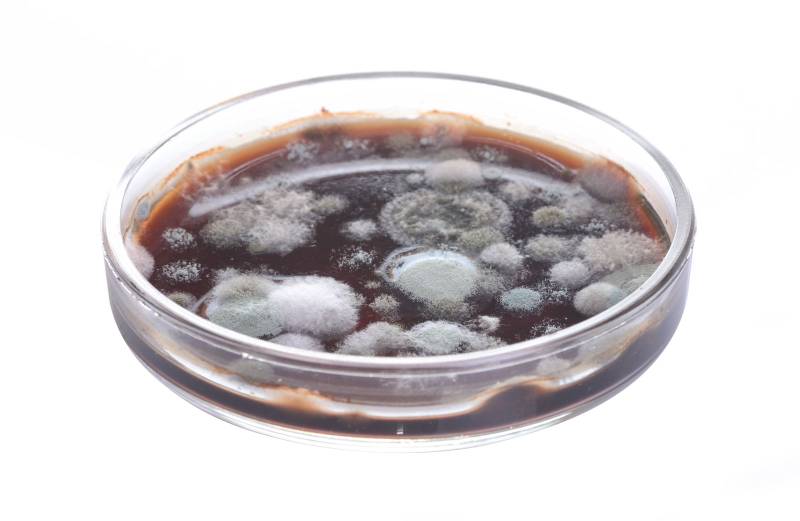
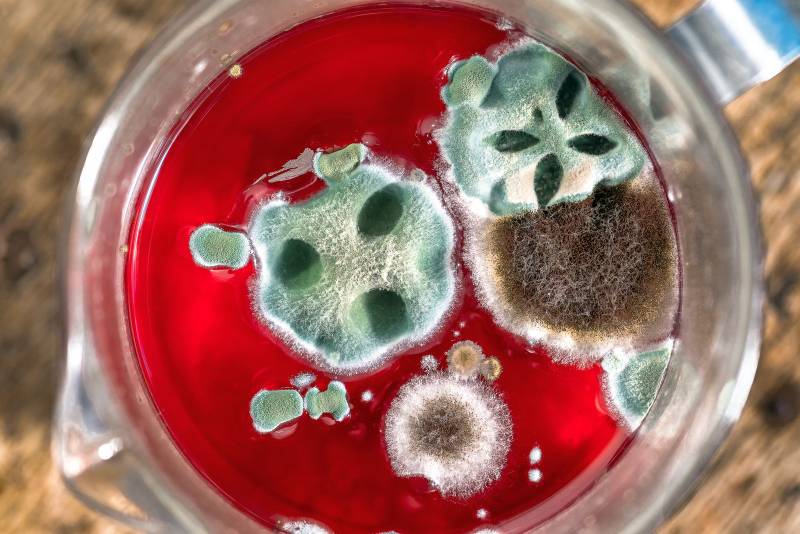
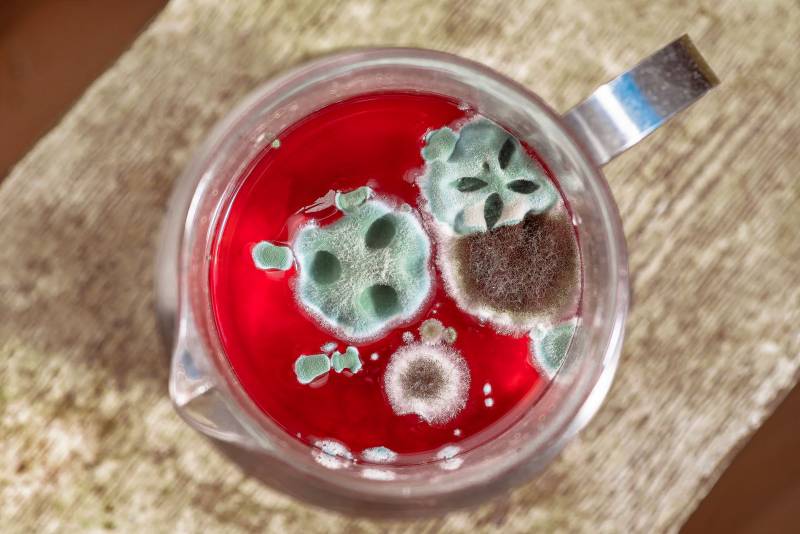
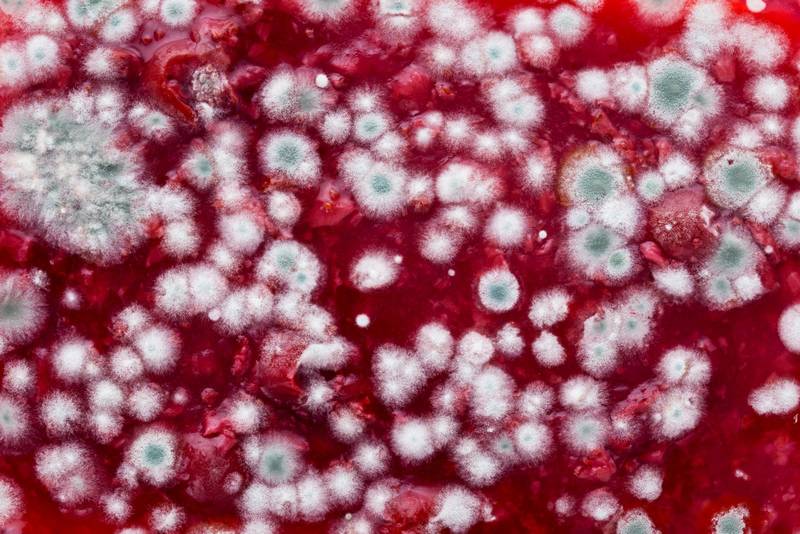
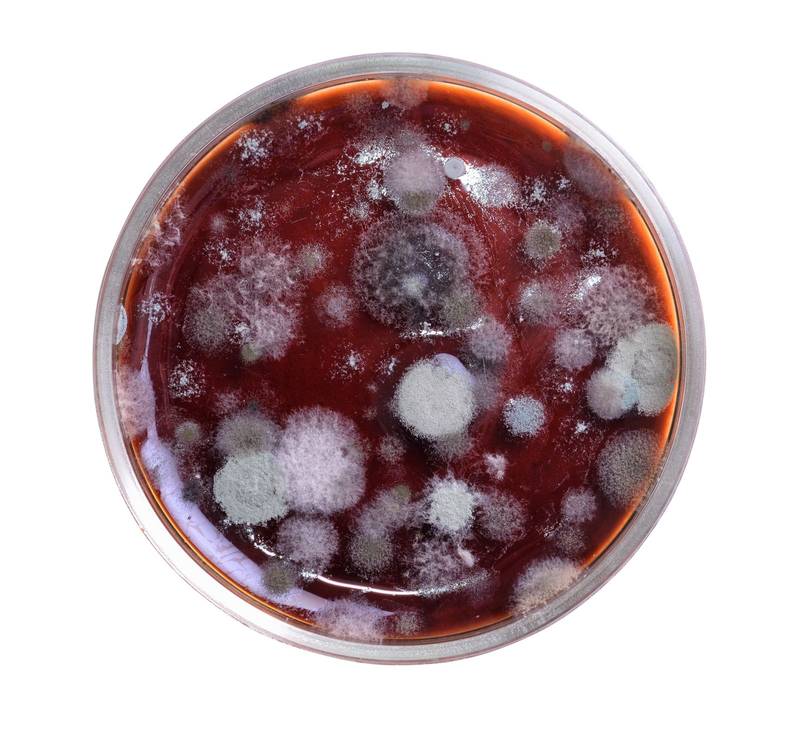

File type
: Any
: Fotos
: Vectores
: Videos
Sort by
: Random
: Colourbox Curated
: Newest
Orientation
: Any
: Horizontal
: Vertical
Licencia
: Stock
: Editorial
Resolución
: Any
: Min. A4 at 300 dpi
: Min. A3 at 300 dpi
Color
: Any
Safe search
: On
: Off
Display Size